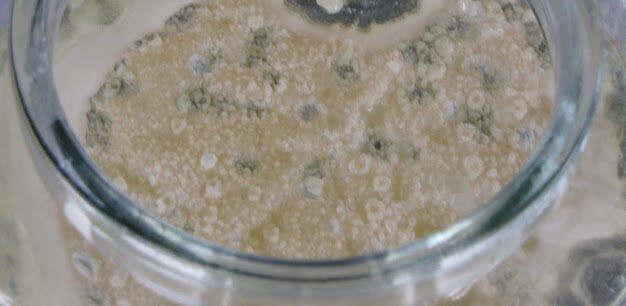

Mümkün olduğu kadar, neredeyse her hafta kendi ekmeğimi hazırlıyor ve haftanın geri kalanında tüketiyorum. Ekmeğin yanı sıra turşu, sirke, kompost ile ilgilendikçe, ortak yaşam alanını paylaştığımız diğer canlılar üzerine daha fazla düşünmeye başladım ve gördük ki farkındalıkla doğru orantılı olarak yapılabileceklerin kapsamı da çeşitlenerek artıyor. Neden EcoDiurnal? sayfasında değindiğim gibi, bir plan doğrultusunda içerikleri ilerletiyor ve mümkün olduğu kadar birden fazla temaya değinmeye çalışıyorum. Bu hedefler doğrultusunda yakın zamanda yaşam alanımda da bir takım değişiklikler yapmam gitmem gerekti; 2017 yılı içerisinde, daha büyük bir alanda daha kapsamlı ve detaylı çalışmalar yaparak sonuçlarını paylaşabileceğim. Bu yazıda değineceğim konu, yine mekan değişikliği içerisinde ve üretim aşamasında özellikle dikkat ettiğim: kontaminasyon.
Kombucha çayımın 3. ayında anne ve yavru SCOBY kontamine olunca atmak durumunda kaldım, yaşadığım burukluğu anlatamam. SCOBY yabancı bakteri ve mantarlara karşı oldukça dirençli olsa da bazı durumlarda, çoğu zaman yüzeye/kapağa temas durumlarında kontaminasyon söz konusu olabiliyor. Bu durumu anlamak oldukça kolay. SCOBY yüzeyinde tüylenme, çoğu zaman renkli nokta nokta alanlar, küflenmeler varsa ve kokusu keskin ve hoş olmayan bir hale gelmişse iş işten geçmiş demektir. Dolayısıyla, kombucha ve diğer fermente gıdaları da düşünerek fermantasyon alanını sürekli hareket olan alanların dışında, gerekmedikçe giriş-çıkışın olmayacağı uygun bir noktaya taşımam ve gıdaların daha dengeli, ölçülü hazırlamam gerekiyordu. Bu işlem için ışıklandırmadan, rafların düzenine, malzemelerin bulunacağı alanın planlanmasından kullanım alanlarının ayrıştırılmasına kadar bir çok düzenleme söz konusu oldu elbette. Bu düzenlemelerden bahsetmeden önce yazının üzerine kurulu olacağı kontaminasyona değineceğim. Ardından da, gıdaları nasıl daha sağlıklı bir şekilde muhafaza ederiz, nasıl malzemeler ve teknikler kullanabiliriz sorularına cevaplarla devam edebilirim.
Öncelikle, temel bir bilgi vermek istiyorum. Kabaca hesaplama yapmak gerekirse, bir bakteri uygun koşullarda (ılık, nemli ve besince zengin) yaklaşık 20 dakikalık bir zamanda tekrar bölünecek duruma gelebiliyor. Bu hızda üreyen tek bir bakteri, eğer sınırlandırıcı etkenler olmasaydı ve süreç geometrik dizi şeklinde ilerleseydi 24 saatte yaklaşık 2000 ton ağırlığında bir bakteri kitlesini meydana getirebilirdi. Neyseki, durum bu kadar endişe verici bir şekilde seyretmiyor.. Çünkü, bakteriler çok kısa zaman içerisinde elverişli olan bu ortamdaki su ve besin maddelerini tüketirler. Bu tüketimle birlikte ortamda alkol ve asitli bileşiklerle birlikte bakteriler için elverişsiz diğer artıklar da oluşmaya başlıyor.
Ortamda oluşan ve biriken bu maddeler bakterilerin yeterli beslenememesine, zarar görmesine ve ölmesine neden olarak sınırlandırıcı görevi görüyor. Böylece, bakteri yoğunluğundaki bu artış, yine bakterilerin kendi faaliyetleri sonucu dengeleniyor. Hatta kimi durumlarda, ortamdaki zehirli maddelerin yoğunluğuna bağlı olarak ölüm oranı daha da artarak ortamdaki bütün bakterilerin de ölmesine de neden olabilmekte. Unutmadan ekleyeyim, birçok bakteri +100°C de ölseler de endosporlar (bir bakterinin ortamın dış etkilerinden korunmak amacıyla aldığı şekil) ölmeden uzun süre dayanım gösterebilirler. (bkz. Control of Microbial Growth).

Konuya giriş yapmak biraz vakit aldı, kabul ediyorum. Ancak, hem kendi adıma hem de paylaştığımda konunun yüzeysel kalmaması adına detaylandırma yapmanın uygun olacağını düşündüm.
Kontaminasyon Nedir?
Kontaminasyon, bir ortama herhangi bir yolla istenmeyen maddelerin/kirlerin/atıkların/mikroorganizmaların bulaşması veya bulaştırılması olarak ifade edilebilir. Temiz bir ortamın kirlenmesi, niteliğinin bozulmaya başlamasıyla “kontamine” olan bu ortam istenen/beklenen yapısal özelliklerini gösterememeye ve hatta zamanla kaybetmeye başlayacaktır.
Bulaşma/bulaştırma, farklı ortamlarda kullanılan malzemelerin karışması, yabancı maddeyle saflığını kaybetmesi, enfekte olması, artık barındırması, birbiriyle temas etmesiyle söz konusu olabileceği gibi, ortam havalandırmasının düzgün olmaması, kombucha örneğinde olduğu gibi ortamın farklı bir yüzeyle temas etmesi gibi şekillerde de söz konusu olabilmektedir. Bir mikrobun, hastalığın, bakterinin veya virüsün diğer bir canlıya ulaşması ve burada üremesi uygun şartlar söz konusu olduğunda oldukça kolay ve hızlı bir şekilde gerçekleşebilmektedir. Özellikle gıdaların bulunduğu, işlendiği ortamlar mikropların bir gıdadan diğerine aynı bıçak, kesme tahtası veya diğer aletlerle geçmesi için oldukça uygun şartlar barındırmaktadırlar. Burada gıdaların çiğ ya da pişmiş olması gibi bir ayrım olduğu düşünülmesin. Çünkü, tamamen pişmiş bir gıda eğer çiğ gıda ile temasa geçer veya çiğ gıdadan patojen geçerse tekrar kontamine olabilir.
Gıdaların Kontamine Olması
Gıdalara bulaşan zararlı mikroorganizmaların büyük bir kısmı sağlıklı hayvanların genellikle bağırsaklarında bulunmaktadır. Et ve kanatlı hayvan etlerinin karkasları (bkz. karkas) kesim esnasında çok az miktarda işkembeye temas ettiğinde bile kontamine olabilmektedir. Aynı şekilde, taze meyve ve sebzeler de hayvan gübresi, insani atıklar vs. ile kontamine olmuş suyka yıkanır veya sulanırsa kontamine olabilir.
Karkas: Her ırktan kasaplık hayvanın usülüne uygun olarak kesilmiş, yüzülmüş, baş ve ayakları ayrılmış, iç organları, böbrekleri ve üreme organları, idrar kesesi ve bunların bağları, yemek borusu çıkarılmış, böbrek yağları, salkım yağları ve pelvis boşluğu yağları alınmış, kuyruğu kesilmiş bütün haldeki gövdeleridir.
Üretim ve yetiştirme süreçlerinin dışında, gıdaların işlemleri esnasında, işleme hattı da mikroplarlar için elverişli olabilir. Üretim hattının kendisi bu gibi bir karşılaşmaya normal şartlar altında korunaklı olsa da, gıdayla uğraşan enfekte kişi sayesinde veya hammaddeden çapraz bulaşmayla mikropların yayılımı mümkün olabilmektedir.
Kontamine Olmuş Gıdanın İşlenmesi
Kontamine olmuş gıdanın işleniş şekli de fark oluşturabilmektedir veya salgın oluşup oluşturmayacağını belirleyebilir. Birçok bakterinin hastalığa neden olması için belirli bir yoğunluğa ulaşması gerekmektedir. Kabaca, hafif kontamine olmuş bir gıda bir gece sonra yüksek enfekte edici etkiye sahip olabilir. Diğer yandan, hafif kontamine olmuş bir gıda tam olarak soğutulursa, istisnai durumlar dışında (Listeria monocytogenes ve Yersinia enterocolitica gibi iki gıda kaynaklı bakteri aslında buzdolabı koşullarında gelişebilir) bakteri daha fazla çoğalamayacaktır. Genel olarak, soğutma veya dondurma işlemi bakterilerin gelişmesini hemen hemen engeller. Ancak bu engelleme tamamen durmasına değil, aktivitelerin askıya almasını ifade eder. Soğuğa ek olarak, yüksek tuz, şeker ve asit içeriğine sahip gıdalar da bakterilerin gelişmesini engelleyebilmektedir – ki halihazırda yayınladığım ve ilerleyen süreçte yayınlayacağım içeriklerin de temelinde bu konu olmakta (bkz. reçel, salamura, turşu, sirke, fermentasyon vs.).
Peki, ya ısı?
Isı mikropları öldürme konusunda etkili olabilmektedir. Şayet gıdanın iç sıcaklığı 78°C olacak şekilde birkaç saniye ısıtılırsa virüsler, parazitler ve bakteriler istisnai durumlar dışında (Bacillus ve Clostridium bakterileri spor olarak adlandırılan ısıya dirençli bir yapı oluştururlar) zarar göreceklerdir.
Çapraz Kontaminasyon Nedir?
Çapraz kontaminasyon, bakteri ve virüslerin kontamine olmuş bir yüzeyden, kontaminasyona maruz kalmamış başka bir yüzeye transfer olmasıyla medyana gelmektedir. Çapraz kontaminasyon gıda kaynaklı hastalıklar ve gıda zehirlenmeleri için anahtar bir kelimedir. Çapraz kontaminasyon dört ana kaynağa sahiptir: Gıdalar, insanlar, ekipman ve çalışma alanları.
Çapraz kontaminasyon çeşitleri nelerdir?
- İnsan elinden gıdaya bulaşma
- Gıdadan gıdaya bulaşma
- Ekipman veya gıdanın temas ettiği yüzeyden gıdaya bulaşma
Ayrıca, gıda ile ilgili yapılan işlemlerde özellikle aşağıdaki gibi durumlardan kaynaklanan çapraz kontaminasyonlar olduğu tespit edilmiştir.
- Tezgah üzerineki paketler,
- Çalışma tezgahlarının dezenfekte edilmemesi,
- Buzdolabı vb. soğutma ekipmanları,
- Eldiven kullanımından önce ellerin yıkanmaması,
- Kesme tahtasına birden fazla çeşit gıdanın aynı süreçte temas etmesi,
- Dezenfektan konsantrasyonlarının doğru yoğunlukta olmaması.
Peki, çapraz bulaşmayı önlemek için neler yapabiliriz?
- oğrudan tüketime sunulacak gıdaların çiğ ürünlerle temas etmemesine, ayrı yerlerde depolanmasına ve ayrı ekipmanlarla işlenmesine dikkat edilebilir.
- Farklı gıda işleme süreçlerinde ekipmanlara temas edildikten sonra doğrudan tüketime sunulacak gıdalarda aynı ekipmanların kullanılmamasına dikkat edilebilir.
- Doğrudan tüketime sunulacak gıdalara mümkün olduğu kadar çıplak elle temas etmemeye özen gösterebilir ya da farklı bir eldiven kullanılabilir.
- Üretim ve depolama alanlarında çöplerin uzun süre durmamasına dikkat edilebilir.
Özetle, mümkünse doğrudan temastan kaçınmalı, farklı ekipmanlar kullanmalı ve farklı gıdaların birbirleriyle ve yüzeyle temasını mimimumda tutmaya özen göstermeliyiz.
Kontamine Besin Yedikten Sonra Ne Olur?
Çoğu zaman, kontamine besin tüketilmesinin ardından besin zehirlenmesi durumuyla yüzleşiriz ve bu besin zehirlenmeleri genellikle aniden başlar. Kontamine olmuş bir besin tüketildikten sonra hastalık belirtileri yaklaşık 30 dakikayla 72 saat arasında ortaya çıkabilir. Şiddetli karın ağrıları, karında kramplar, bulantı, ishal, kusma gibi sindirim sistemi sorunlarının yanı sıra bazen ateş de görülebilir. Bu etkiler bakteri veya toksine, besinin ne oranda kontamine olduğuna, tüketilen miktara ve kişinin bakteriye karşı gösterdiği duyarlılığa göre değişiklik gösterebilmektedir. Hatta, aynı kontamine besini tüketen farklı kişilerde dahi belirtiler farklılıklar gözlemlenebilir.
Bozulmuş ve kontamine olmuş gıdaların tüketimi, özellikle doğa şartlarında, üzerinde daha da önemle değerlendirilmesi ve dikkatli olunması gereken konulardan arasındadır. Sonuç hem hayati bir boyuta ulaşabilir hem de basit düzeyde faaliyetinizi oldukça olumsuz bir süreçle sekteye uğratabilir.
Kaynakça nedir?
- Besin Zehirlenmeleri, Dr. Sevim Coşkun, Bilkent Üniversitesi
- Kuru Çayda Bakteriyolojik ve Mikolojik Kontaminasyonun Araştırılması, Yard. Doç. Dr. Şengül Alpay Karaoğlu, 2002
- Human Hands and Fingernails
- Gıda Kaynaklı Virüsler: Hijyen ve Güvenlik, Prof. Dr. Mustafa Hasöksüz, İstanbul Üniversitesi Veteriner Fakültesi, Viroloji Anabilim Dalı
- Gıda Endüstrisinde Mikrobiyal Kaynaklı Kontaminasyonlar ve Önlenmeleri, Hanife Kalafatoğlu, 1995
- New analysis reveals human mouth carries more germs than expected
- The skin microbiome
- Comparative surface-to-hand and fingertip-to-mouth
transfer efficiency of gram-positive bacteria, gram-negative
bacteria, and phage